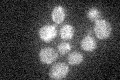
YNL199C
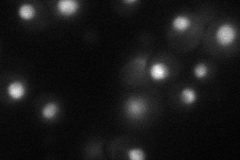
YNL199C
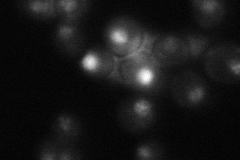
YNL199C
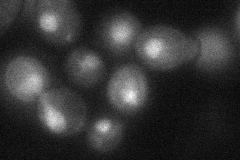
YNL199C
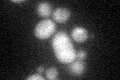
YNL199C

View description
Transcriptional activator of genes involved in glycolysis; interacts and functions with the DNA-binding protein Gcr1p
Localization:
Intensity:
Fold change:
Significance:
-
C’ GFP library in SD
below threshold18.64 -
N' NOP1pr-GFP in SD
nucleus54.7303 -
N' TEF2pr-mCherry in SD

nucleus69.8054 -
N' NATIVEpr-GFP in SD
punctate,nucleus23.6856 -
N' TEF2pr-VC and Cyto-VN in SD
nucleus36.237 -
C’ GFP library in SD+DTT
cytosol16.380.87No -
C’ GFP library in SD+H2O2

cytosol18.390.98No -
C’ GFP library in Starvation Media

cytosol15.030.8No -
C’ GFP library on the background of Pup2-DaMP

below threshold -
C’ GFP library on the background of CCT mutant

below threshold19.66181.0543No
